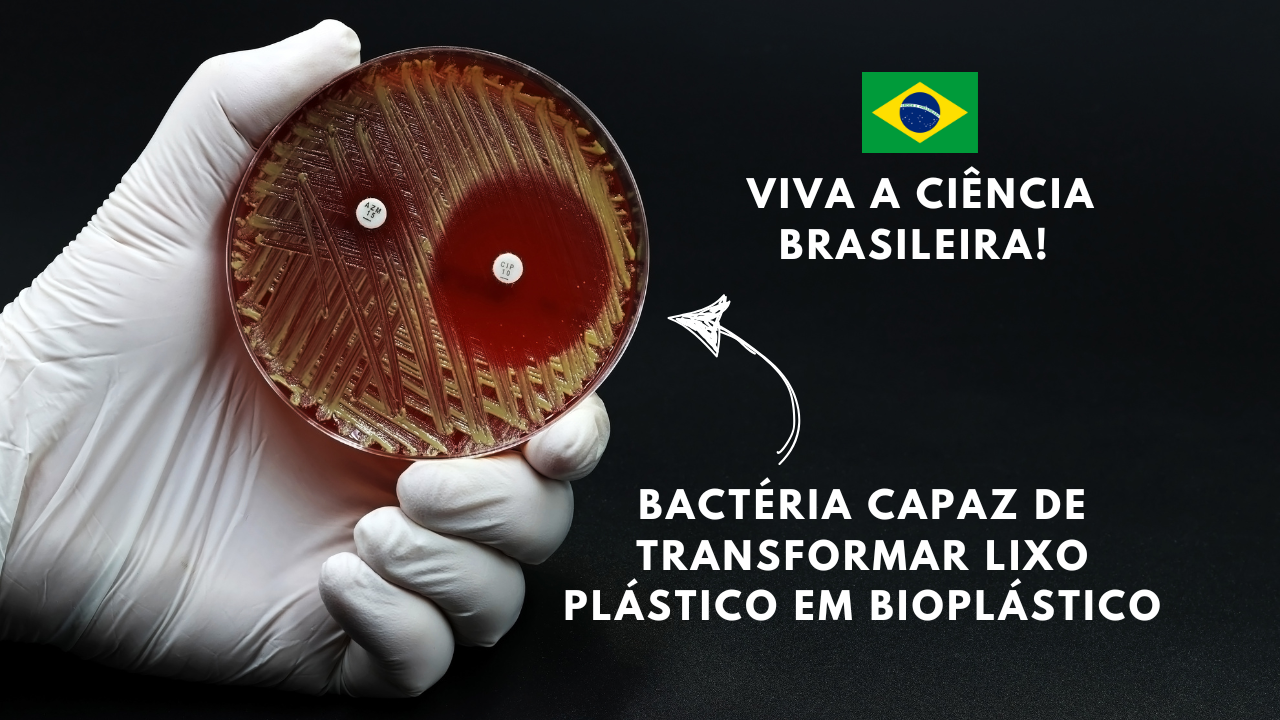
Pesquisadores brasileiros descobriram bactérias capazes de transformar plástico em bioplástico, uma solução eficiente para o material

Brazilian Researchers Discovered Bacteria Capable of Turning Plastic into Bioplastic, Offering an Efficient Solution for the Material.
The increasing amount of waste on the planet has become one of the biggest environmental challenges. In search of ways to address this problem, Brazilian researchers identified a bacteria that has the capacity to decompose plastic, especially PET, found in bottles and packaging. This bacteria transforms plastic into bioplastic, providing a more sustainable and high-quality solution.
The discovery could revolutionize the way we deal with plastic waste and open doors for the production of new materials, such as bioplastic, useful in packaging and biomedical applications.
The Study on the Bacteria and the Contribution of the Researchers
The research that led to the discovery of the BR4 bacteria was conducted with the support of FAPESP and was led by researcher Fábio Squina from the University of Sorocaba.
-
Oceanographer Turns Abandoned Fishing Nets from Brazilian Waters into Bags, Creating Jobs and Earning Over $7,000 Monthly
-
Australia deploys poisoned sausages and uses traps, shooting, and fences in a battle against invasive cats that kill over 1.5 billion native animals annually, threatening more than 200 species.
-
NASA Rover Captures “Tired Face” on Mars, Highlighting Human Brain’s Tendency to See Faces in Rock Formations
-
Ancient Stone City in the Desert, Once Home to 30,000, Puzzles Scientists with Nabateans’ Water Mastery 2,000 Years Ago
The study, published in the journal Science of The Total Environment, shows how a bacteria can efficiently decompose plastic and transform it into bioplastic.

This bioplastic, unlike recycled plastic, is of high quality and can be used in various sectors, such as in the production of packaging and even in biomedical applications.
The work of the researchers is an important step towards reducing the impact of plastic waste on the environment and finding more effective alternatives for plastic recycling.
How the Bacteria Transforms Plastic into Bioplastic
To understand how a bacteria transforms plastic into bioplastic, a study analyzed soils contaminated with plastic, where microbial communities capable of decomposition, such as PET, were identified.
The Pseudomonas sp. BR4 bacteria stood out for its ability to not only decompose PET plastic but also to generate polyhydroxybutyrate (PHB), a highly durable and flexible bioplastic.
This bioplastic generated by the BR4 bacteria can be used in the production of packaging and in various other applications.
When enriched with hydrox valerate (HV), the bioplastic becomes even more useful, gaining ideal properties for use in sectors such as sustainable packaging and biomedical applications.
Furthermore, the study details how the bacteria carry out this bioplastic manufacturing and production process.
By sequencing the genomes of 80 bacteria, the researchers aim to identify the metabolic pathways and transport mechanisms that the bacteria use to degrade plastic and convert the material into bioplastic.
This knowledge is essential for improving the process and for potential applications in other types of plastics, not just PET.
Challenges for Plastic Biodegradation
Although the study showed promising results, the researchers still face challenges.
While the BR4 bacteria is resilient in degrading PET and generating bioplastic, further research is beneficial to refine the technique and expand its applications to other types of plastics.
The potential of the bacteria is not limited to PET, and the researchers believe that with more studies, it will be possible to use the same approach to degrade other fossil-based plastics and convert them into bioplastics, which could be a viable solution for large-scale waste.
With the increasing plastic waste in the oceans and its impact on marine life, the need for innovative solutions such as turning plastic into bioplastic becomes even more urgent.
The discovery of the BR4 bacteria represents an important advancement, but the path to large-scale application of this process requires more research and testing.
A Breakthrough in the Fight Against Plastic Waste
The discovery of the BR4 bacteria, which transforms waste into bioplastic, is a significant advancement in the fight against plastic pollution.
This bacteria not only decomposes PET but also generates a high-quality bioplastic with great potential for use in various fields, such as in the production of packaging and in biomedical applications.
The work of Brazilian researchers is crucial to finding a more effective solution for plastic waste, offering alternatives to the conventional recycling process.
In the future, a technique may be expanded to deal with other types of plastics, thus contributing to a cleaner planet.
SOURCE: FAPESP


 Portuguese
Portuguese  Spanish
Spanish